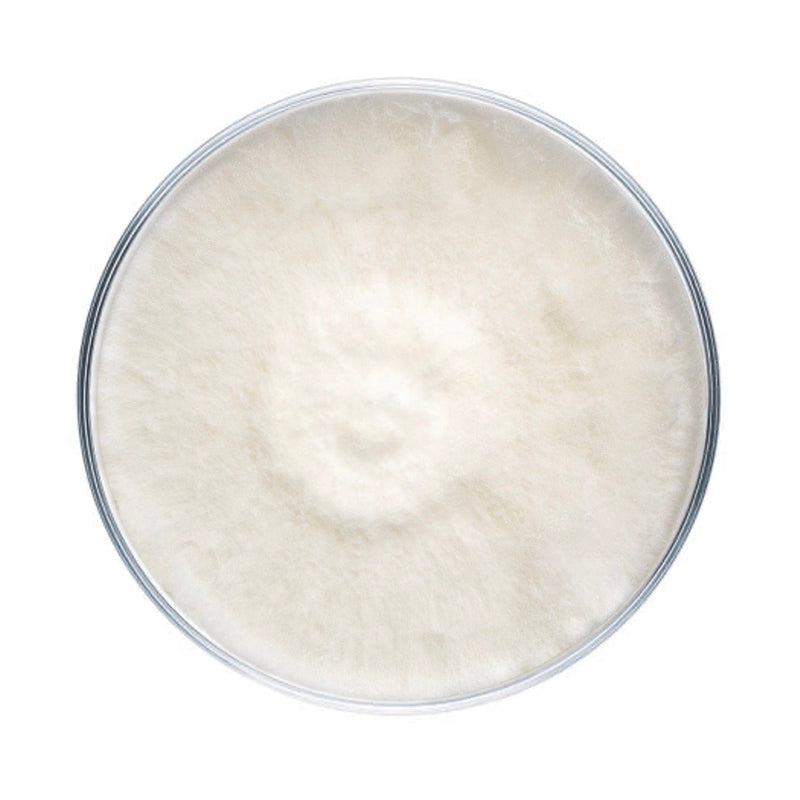
Culture Snow Oyster Mushroom Agar Plate Culture

Snow Oyster Mushroom Plate Culture
Plate cultures are ideal for growers looking to make master bags, inoculate grain, make liquid culture, or make more plates.
Our snow oyster plates are made to order in our in-house lab using medical-grade petri dishes. If properly stored upon arrival, they have a shelf life of approximately 6 months. Snow oyster plates should be stored in the refrigerator to maintain viability. Note that mycelium cultures require basic lab skills. Handle using sterile technique to prevent contamination.
For complete descriptions of available snow oyster strains, click on the names below.
NSPO3 - Snow White Oyster
Pleurotus ostreatus. A vigorous, high-yield commercial strain that produces very dense clusters of fleshy, firm, pure white caps. They have a sweeter flavor and aroma than other oysters and hold their shape and texture when cooked. This strain performs very well during the coldest months of the year but is not recommended for outdoor warm weather production.
Frequently Asked Questions